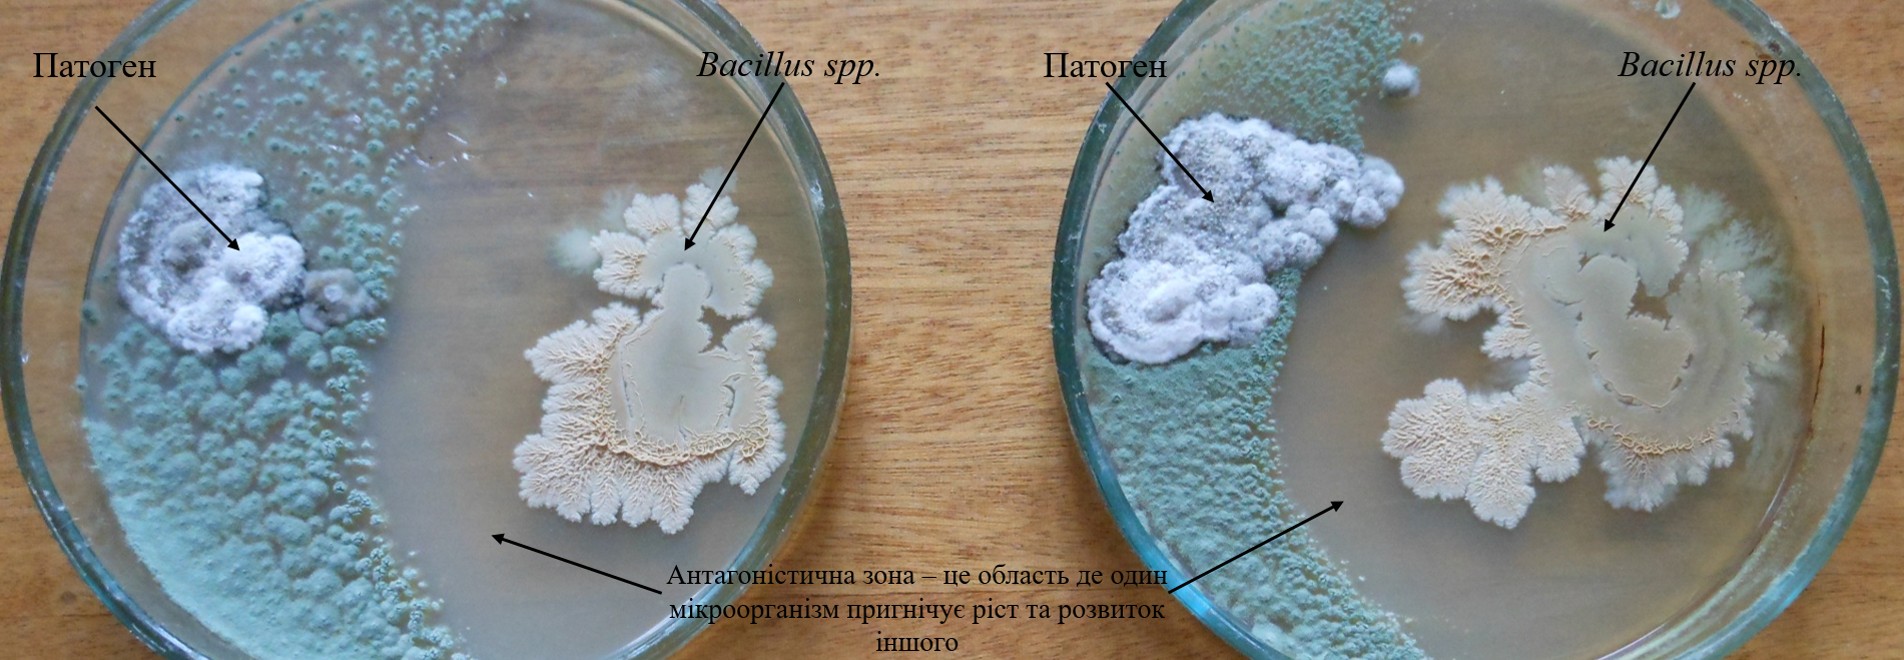
Приклад антагоністичної взаємодії бактерій роду Bacillus з патогеном

Концепція застосування мікробіологічних та хімічних ЗЗР для обмеження розвитку ґрунтових інфекцій
Коренева система рослини — це один із найважливіших органів у формуванні майбутнього врожаю. Саме завдяки кореневій системі рослини засвоюють поживні речовини та вологу. Тож захист кореневої системи — це одна із найважливіших цілей, яку ставить собі агроном.
Поверхневу вегетативну масу можна захищати, обробляючи її найрізноманітнішими фунгіцидами, але здебільшого їхній вплив на кореневу систему рослини мінімальний або відсутній. Протруйники захищають рослину до 40-50 діб і за сприятливих умов коренева система може інфікуватись патогенними мікроорганізмами. Ознаки прояву залежать від виду патогена та ступеня ураження рослини.
Найбільш поширеними і найнебезпечнішими патогенами для соняшника є Verticillium dahliae Klebahn, гриби роду Fusarium та Sclerotinia sclerotiorum, які викликають вертицильозне в’янення, фузаріозну кореневу гниль та склеротиніоз.
При вертицильозному в'яненні хвороба уражує судинну систему рослин, що призводить до порушення водного обміну та в'янення. Спершу відбувається пожовтіння і знебарвлення листків з нижніх ярусів рослин, згодом утворюються некротичні плями.
Фузаріозна коренева гниль на вегетативній масі проявляється у вигляді некротичних плям з країв листків, пожовтіння та повного відмирання листків. На центральному корені з’являються глибокі тріщини, бурі плями, а бічні відростки недорозвинені. Це знижує розвиток азотфіксуючих мікроорганізмів до мінімуму, оскільки бульбочки також інфікуються. Рослини завчасно припиняють вегетацію, якість урожаю низька, як і його кількість. Зерно такого урожаю використовувати на насіння ми не рекомендуємо.
Читайте також: Стратегія контролю склеротиніозу: поєднання агротехнічних, біологічних та хімічних заходів
Склеротиніоз або біла гниль на вегетативній масі поширюється за допомогою спор гриба-збудника, тоді як коренева система уражується міцелієм від його склероцій. Склероції можуть зберігатися в ґрунті до восьми років. Неймовірно вірулентний гриб: за 20-30 діб від моменту інфікування може повністю знищити рослину.
Боротьба з кореневими інфекціями надзвичайно складна через фізіологію рослин та властивості фунгіцидів. Тому для захисту сільськогосподарських культур має бути задіяна низка заходів, спрямована на обмеження розвитку патогенів. Зокрема, сівозміна, сортооновлення, застосування хімічних протруйників насіння, знищення рослин-носіїв інфекції (бур’яни, падалиця соняшнику, ріпаку).
Не слід також забувати про ефективність мікробіологічних засобів захисту рослин. Вони насичують ґрунт корисною мікрофлорою, яка в конкуренції з патогенами обмежить їхній розвиток.
Мікробіологічні препарати в своєму складі можуть містити один вид мікроорганізмів або декілька. Наприклад:
- Бактолайв Актив Соіл містить штами бактерій Bacillus spp.
- Бактолайв СІД — Trichoderma harzianum, Bacillus spp.
Як правило, такі препарати містять елементи живлення, органічні речовини (гумати, витяжки з водоростей) та фітогормони.
Як працюють мікробіологічні препарати?
Ґрунт насичений величезною кількістю мікроорганізмів як корисними, так і патогенними, і між ними існують різні види взаємодії, такі як симбіоз, антагонізм, коменсалізм, сателізм тощо. При створенні мікробіологічного препарату головною метою є підбір штамів та різновидів мікроорганізмів таким чином, щоб вони мали по відношенню до рослин тип взаємодії симбіозу (або коменсалізм), а по відношенню до патогенних мікроорганізмів — антагонізм.
Одним із найсильніших антагоністів в природі серед грибів є Trichoderma, а серед бактерій — Bacillus.
Таким чином, обробляючи насіння мікробіологічним препаратом, ми заселяємо майбутню кореневу систему мікроорганізмами, які проявляють сильну антагоністичну дію по відношенню до патогенів. Так ми суттєво зменшуємо імовірність інфікування кореневої системи патогенами, коли дія хімічного протруйника уже відсутня.
Команда Himagro M пропонує концепцію застосування хімічних та мікробіологічних ЗЗР для обмеження розвитку патогенних мікроорганізмів.
Схема контролю ґрунтових патогенів мікробіологічним препаратом в комбінації з хімічними ЗЗР
Органічні решки є харчовою базою для мікроорганізмів, тому Крок 1 — застосування препарату Бактолайв Актив Соіл в нормі 0,5-1,0 кг/га як деструктора (знезараження) стерні. Він зменшує популяцію патогенів шляхом анатгоністичних відносин. Можна його поєднати в баковій суміші з гліфосатами: Тотал, Тотал К, Тотал Пауер.
Крок 2 — використання Бактолайв Актив Соіл у нормі 0,5-1,0 кг/га із РКД або методом фертигації. Можна змішування з рідкими комплексними добривами (окрім КАС). Забезпечує стимуляцію розвитку кореневої системи, захист від ґрунтових збудників хвороб, мобілізує поживні речовини для рослини.
Крок 3 — обробка насіння мікробіологічним препаратом Бактолайв СІД.
Мікробіологічний препарат необхідно розчинити у воді (без антисептичних компонентів таких як хлор, мідь) та додати в загальну бакову суміш для протруєння насіння.
Мікробіологічні препарати сумісні в одній баковій суміші із препаратами: Бімакс, Номінал Ультра, Сидгард, Тебузан Ультра, Тіабен Т, Тріолан. Оброблене насіння зернових культур може зберігатися 60 діб до сівби.
Читайте також: Соняшник за системою Clearfield: реальний кейс з Житомирської області
Крок 4 — своєчасне застосування фунгіцидних бакових сумішей:
- Бредлі (0,2 л/га) + Тонус (0,6 л/га),
- Метакарб (1,2 л/га) + Бредлі (0,2 л/га),
- Тіофен Екстра (1 кг/га) + Тонус (0,6 л/га),
- Тіофен Турбо (1 л/га) + Байзафон (0,4 кг/га) + Тонус (0,5 л/га),
- Жокей Екстра (0,6 л/га) + Бредлі (0,2 л/га).
До бакових сумішей також можна додати мікробіологічний препарат Бактолайв Актив Соіл (0,5 кг/га) як еліситор, біофунгіцид та джерело елементів Са і Mg.
Дуже важливо обробки проводити препаратом або сумішшю препаратів з цілеспрямованою дією, щоб результат був максимально ефективним. Адже за значного ураження ми можемо лише стримувати розвиток хвороби.
Himagro M
Думка редакції SuperAgronom.com може не збігатися з точкою зору автора. Редакція не несе відповідальності за достовірність і тлумачення наведеної інформації і виконує роль виключно носія.